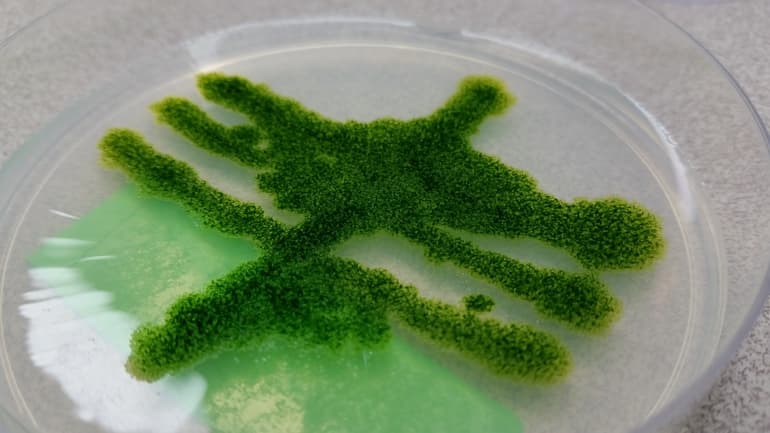
Цианобактерии &mdash; строение, роль и особенности жизнедеятельности

Цианобактериями называется отдел одноклеточных прокариотов в виде синезеленых водорослей, обладающих способностью к фотосинтезу.

Они являются первыми живыми организмами, вырабатывающими кислород из углекислого газа и воды.
С помощью цианобактерий на Земле образовался озоновый слой, осуществляющий защиту планеты от воздействия ультрафиолетовых лучей.
- История открытия и исследования
- Особенности строения
- Значение и применение синезеленых водорослей
- Биохимический состав
- Разновидности цианобактерий
- Особенности питания
- Ареал обитания
История открытия и исследования
В биологии определение, что такое цианобактерии, было сформулировано нидерландским ученым Антонио Ван Левенгуком в XVIII столетии. Он занимался изучением бактериальных клеток совместно с французским химиком Луи Пастером и выявил особенности строения и жизнедеятельности водорослей. В результате исследований было обнаружено, что первые организмы, способные производить кислород, появились на Земле несколько миллионов лет назад. Благодаря изобретению микроскопа, исследователи смогли изобразить точную структуру цианобактерий.
Современные исследования первых бактерий, способных синтезировать кислород, проводятся учеными-палеонтологами при помощи изучения останков водорослей, сохранившихся на древних горных породах.
На основе анализа исследователи выявили, что эти организмы обладают высокими показателями выносливости. Они сохранили свое строение после изменений в температурном и химическом составе планеты.
Во второй половине XX — начале XXI вв. синезеленые водоросли были включены в царство бактерий. Они образовали отдельное подцарство цианобактерий.
В нынешнее время эти организмы продуцируют до 40% органических веществ и кислорода на планете.
Особенности строения
Цианобактерии образованы шаровидными, эллипсоидными и цилиндрическими клетками, соединенными в цепи. Клеточные структуры покрыты тонкой пленкой, состоящей из мембран. Для отдельных представителей цианобактерий характерно наличие слизистого чехла, выполняющего защитную и соединительную функции. В состав морских водорослей входят газовые вакуоли, выполняющие роли жгутиков. Они позволяют организмам перемещаться по воде и сохранять равновесие во время передвижения. Если цианобактерии теряют свойство плавучести, то они всплывают на поверхность.
В составе цианобактерий отсутствуют следующие элементы эукариотических клеток:

- хроматофоры ;
- митохондрии ;
- эндоплазматическая сеть ;
- клеточное ядро ;
- вакуоли с клеточным соком.
Сходство водорослей и эукариотов заключается в идентичном наборе пигментов, наличии питательных веществ и отсутствии жгутиковых связей.
Также эукариотические клетки способны осуществлять фотосинтез.
Значение и применение синезеленых водорослей
В природе цианобактерии играют роль продуцента. Они наполняют почву азотными соединениями и органическими веществами. Главной функцией водорослей является воспроизводство кислорода — химического элемента, необходимого для жизни большинства живых организмов на планете.

Цианобактерии используются в сельскохозяйственном секторе для повышения урожайности. Они способны фиксировать азот из атмосферы и обогащать им почву, что позволяет выращивать культурные растения на неплодородной земле.
Отдельные виды водорослей используются для кормления небольших животных. Они доставляют организму питательные вещества: белки, жиры, углеводы и витамины.
В азиатских странах из цианобактерий изготавливают пищевые белки и приправы для улучшения вкусовых качеств блюда.
Биохимический состав
Цианобактерии имеют сине-зеленый цвет. Зеленую окраску водорослям придает хлорофилл. Наличие синего цвета обусловлено присутствием пигментов: фикоцианина и алофикоцианина. Если в фотосинтезирующем орагнизме присутствует фикоэритрин, то он приобретает красный оттенок. Отдельные подвиды имеют в своем составе лютеин, ксантофил и зеаксантин. Эти вещества позволяют запасать углеводы, волютин, цианофицин и иные питательные элементы.

Цианобактерии располагают фотосинтетическим аппаратом, осуществляющим процесс образования органических веществ и кислорода.
Главными компонентами для проведения этого биохимического процесса являются вода, углекислый газ и сера. Они предоставляют отрицательные частицы для расщепления вещества.
В результате образуются химические элементы, требуемые для дыхания живых существ. Фотосинтез может происходить как в темное, так и в светлое время суток.
Разновидности цианобактерий
Существует свыше 1500 видов цианобактерий.
Они были классифицированы по общим признакам и объединены в классы:

- Хроококковые: объединяют фотосинтезирующие организмы, имеющие одиночную или колониальную форму. Для них характерно наличие большого количества слизи, выделяемой клеточными структурами.
- Плеврокапсовые: включают в себя бактерии, относящиеся к подвидам Плеврокапсы, Дермокапсы и Микосарцины. Они способны формировать беоциты — репродуктивные клетки.
- Оксиллатории: объединяют вегетативные клетки, осуществляющие деление бесполым способом. Они образуют трихому — структуру из слизи — и делятся внутри нити цианобактерий.
- Ностоковые: объединяют фотосинтезирующие организмы в форме трихом, осуществляющие половое размножение. Они способы образовывать цветные налеты и обладают свойством криофильности — легкой адаптации в условиях пустыни.
- Стигонемовые: включают в себя бактерии вида Фишереллы. Они осуществляют половое размножение. Но, в отличие от ностоковых бактерий, могут делиться многократное количество раз в пределах одноклеточного организма.
Эта классификация была представлена американским бактериологом Берджи Дэвидом Хенриксом. Он является создателем справочника по бактериологической систематике, предназначенного для подробного описания всех разновидностей фотосинтезирующих организмов.
Особенности питания
Цианобактерии обладают смешанным способом питания. Они являются автотрофами и могут синтезировать углеводы. Но при изменении среды обитания водоросли приобретают признаки питания гетеротрофов — цветковых растений. Они смогут использовать готовые органические вещества, распадающиеся при меньшем количестве электронов, для проведения фотосинтеза. Отдельные разновидности фотосинтезирующих организмов питаются при помощи хемосинтеза — одновременного синтеза кислорода и фиксирования азота из атмосферы.
Выделяют следующие способы питания фианобактерий:

- Облигатный: организмы растут под воздействием солнечного света и при наличии неорганического источника углерода.
- Факультативный: бактерии осуществляют рост в ночное время суток при использовании энергии органических веществ.
- Фотогетеротрофный: организмы произрастают в дневное время суток при наличии источника солнечного света и углеродных соединений.
- Миксотрофный: бактерии осуществляют автотрофную фиксацию углекислого газа, используя органические соединения в качестве дополнительного источника углерода.
При помощи универсальных типов питания цианобактерии способны расти в экстремальных условиях. Они могут заселять места с недостаточным количеством питательных элементов, создавая условия для возникновения новых живых организмов.
Ареал обитания
Большая часть синезеленых водорослей обитает в пресных водоемах, морях, влажной почве, на скалистой местности, в горячих источниках, полостях тропических листьев, рисовых полях, на ледяных озерах Антарктики и в пустынях. Среда обитания может отличаться в зависимости от типа питания и биохимического состава бактерий. В редких случаях фотосинтезирующие организмы могут вступать в симбиоз с лишайниками и мхами. При помощи симбионта они получают продукты для фотосинтеза.

Отдельные виды цианобактерий имеют в своем составе токсины, отравляющие места их обитания. Они способны вызывать отравления представителей фауны и людей при попадании в искусственные водоемы или водохранилища.
При массовом размножении цианобактерии способны окрасить среду обитания в синий, зеленый или красный цвета. Ареал обитания лишается запасов кислорода и становится непригодным для жизни других организмов.
Цианобактерии могут появиться в аквариуме из-за отсутствия ухода. Они нарушают экологический баланс и наносят вред обитателям этого резервуара. Для борьбы с этими организмами необходимо тщательно промыть аквариум, заменить воду, убрать резервуар в затемненное место и использовать препарат «Эритромицин», предназначенный для удаления цветного налета.